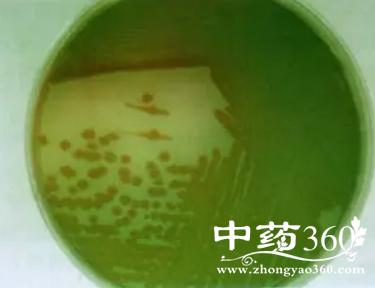

铜绿散的功效 铜绿散治男子妇人阴部湿淹疮
导读:《洁古家珍》:铜绿散处方五倍子(细研)38克 白矾7.5克 铜绿少许 轻粉1克 乳香4克...
《洁古家珍》:铜绿散处方五倍子(细研)38克 白矾7.5克 铜绿少许 轻粉1克 乳香4克
制法上为极细末。
功能主治治男子、妇人阴部湿淹疮。
用法用量洗净掺之。
备注本方在原书中无方名,现据《普济方》卷三○一补。
摘录《洁古家珍》
热点排行
-
分享牛大力壮阳偏方 牛大力壮阳偏方 牛大力壮阳偏方有很多,最有效最简单的方法就是把它和生蚝放在一起煲汤喝, … [详情] -
芎芷石膏汤歌诀 头痛眩晕可服用芎芷石膏汤 处方芎芷石膏汤系由川芎、白芷、石膏、菊花、羌活、藁本组成,具有散风泄热 … [详情] -
逍遥散的组成 逍遥散的功效作用 由逍遥散化裁出了许多方剂,广泛运用于临床各科,多以柴胡、当归、白芍、甘 … [详情] -
温胆汤不适合哪些人喝 温胆汤有什么副作用 说起中药方剂,大家在日常生活中时常都碰见或者听闻某某配方能够治疗什么疾 … [详情] -
乌头汤方解 乌头汤组成 乌头汤方歌 寒湿痹证乌头汤,黄芪草芍配麻黄,说的就是乌头汤方歌!乌头汤处方是什么, … [详情]
好文阅读
-
保健按摩 按摩耳朵可预防疾病 中医经络学说认为,耳朵上遍布穴位,通过对耳朵的按摩就能够起到治疗疾病的 … [详情] -
吃生姜时有哪些要注意的 吃生姜的几个禁忌 有些人吃姜喜欢削皮,这样做不能发挥姜的整体功效。鲜姜洗干净后即可切丝分 … [详情] -
中风如何治疗 中风的偏方有哪些 将干菊花瓣放进打粉机内打成粉末备用。大米洗净用瓦锅煮粥,待粥将成时,放 … [详情] -
丝瓜汤的做法 丝瓜汤怎么做好吃 锅中放猪油和少许食用油,加入丝瓜盐翻炒均匀。 … [详情] -
苹果排石的方法有哪些 网上流行用苹果来排结石的办法,就是将12个左右的苹果榨汁后去掉残渣,然后 … [详情]

















